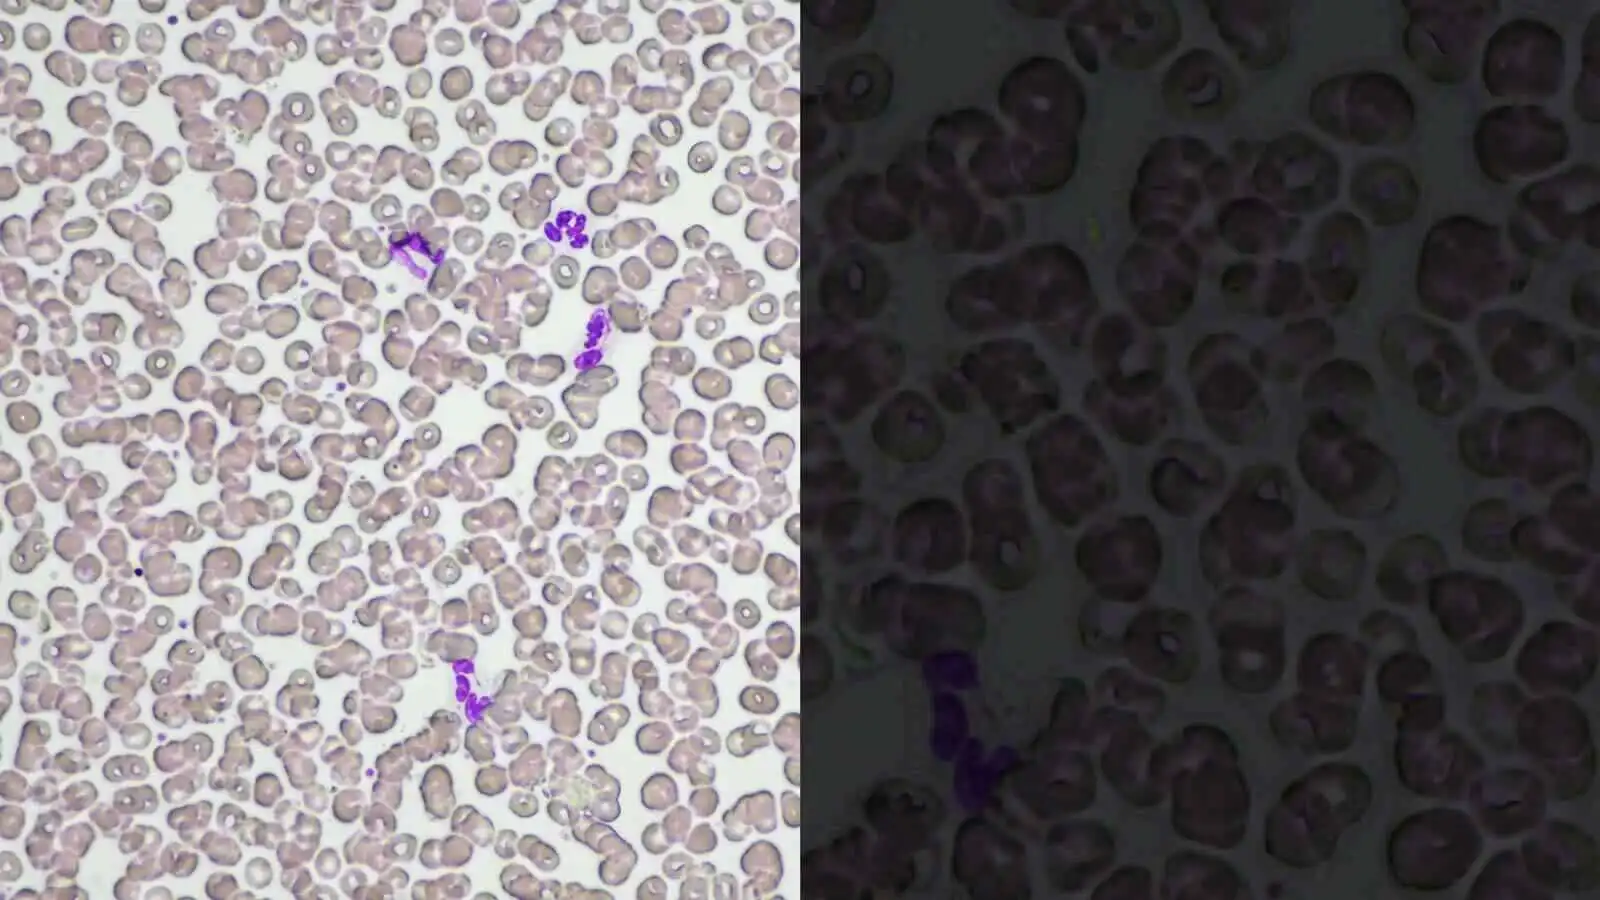
光强度管理 (LIM) 功能

Nikon ECLIPSE Ci-L plus Upright Biological Microscope
“The Nikon ECLIPSE Ci-L plus” is a biological microscope designed with a focus on ease-of-use as well as the health and working styles of people involved in research.
Phone:+86-21-54286005
Microsystem
Endoscopysystem
Energysystem
+86-21-54286005
info@tenmed.net
Room 602, Building 1, No. 111 Luxiang Road (Greenland Park Plaza), Baoshan District, Shanghai, China
“The Nikon ECLIPSE Ci-L plus” is a biological microscope designed with a focus on ease-of-use as well as the health and working styles of people involved in research.
Phone:+86-21-54286005
Microscopy observation is indispensable in a variety of situations. Researchers need to carry out tasks with speed and accuracy, all while maintaining concentration over a long period of time.
“The Nikon ECLIPSE Ci-L plus” is a biological microscope designed with a focus on ease-of-use as well as the health and working styles of people involved in research.
With greater comfort and usability, the Ci series brings revolutionary changes to microscopy observation.

The light intensity management (LIM) function developed by Nikon automatically stores any changes to brightness settings. This helps avoid drastic changes in brightness when switching between different magnifications during observation, thereby helping to mitigate eye strain.
Low-magnification objectives High-magnification objectives Low-magnification objectives High-magnification objectives
The LIM function saves and recalls the optimal brightness level for each objective, eliminating the need to manually adjust the illuminator and change posture every time you switch objective lenses.

The eyepiece tube can be inclined and extended, and the angle of the elbow can be adjusted by changing the height of the handle, so that you can always adopt a posture that suits you, thereby reducing physical strain.

With the addition of a nosepiece spacer, the stage height can be lowered 20 mm from the standard position, reducing strain during frequent specimen change. The stage handle height can also be changed to ensure a comfortable hand position. The stage height can be locked using the refocusing knob, allowing quick refocusing after specimen changes. The stage is coated with a high-durability, scratch-resistant ceramic coating.

Without spacer (left), with spacer (right) Height adjustable stage handle Ceramic-coated stage
Note: The product displayed in the above images is the ECLIPSE Ci-E
Quickly and easily check magnification and brightness settings using the display at the base of the microscope without changing your observation posture.

❶ ECO mode: ON
❷ LIM function: ON
❸ Objective name
❹ Magnification
❺ Brightness state
The scale bar on the PC display changes automatically to match the magnification level, eliminating the need to set the scale manually.
*Sold separately: Software (NIS-Elements D / BR / AR), Nikon recommended camera required

The Eco-illumination is a low-power-consuming, eco-friendly illumination system that produces uniform brightness and reduces the cost and effort of lamp replacement, thanks to its 60,000 hour, high-luminescent LED. By combining a collimator lens, fly-eye optics and LED illumination, bright and edge-to-edge uniform images can be obtained even at high magnifications. The LED illuminator features low-heat generation and provides the same color temperature at every magnification.

One simple click of the image capture button on the microscope base during observation enables the Digital Sight camera to capture the specimen image. Camera control software for tablet PC NIS-Elements L is equipped with a scene mode that can automatically set the optimum shooting conditions for each observation method. Since it has a network function, you can share images with a remote PC.
* NIS-Elements L is not for clinical diagnostic use.

Image capture button NIS-Elements L camera control software for tablet PC

Digital pathology via network
Note: The product displayed above is a different ECLIPSE Ci model.
High-contrast images with neutral background coloration regardless of the magnification range can be captured. This observation technique is suitable for observation of unstained structures.

Phase contrast accessories and objective lenses
Ideal for observing bi-refringent samples such as collagen, amyloids and crystals.
* Two types of analyzer are available: intermediate tube type and nosepiece slider type.

2.8-Dihydroxyadenine crystals, Simple polarizing, Simple polarizing accessories
CFI Plan Fluor 40X
Department of Clinical laboratory, Nihon University Itabashi Hospital
Enables Identification of uric acid crystals by changes in the interference color. This technique is ideal for gout and pseudo-gout tests.
* Two types of analyzer are available: intermediate tube type and nosepiece slider type.:成贯仪器)

Sodium urate crystals, Sensitive color polarizing, Sensitive color polarizing accessories
CFI Plan Fluor 40X
Department of Clinical laboratory, Nihon University Itabashi Hospital
Enables clear observation of blood or minute structures such as flagella. Dry- and oil-type condensers are available. An expander lens is utilized for brighter imaging.

Compact epi-fluorescence attachments that utilize noise terminating mechanisms allow weakly fluorescing specimens to be captured with great clarity and brightness. Both CI-FL epi-fluorescence attachment (incorporates up to 4 filter cubes) and D-FL epi-fluorescence attachment (incorporates up to 6 filter cubes) allow easy switching of filter cubes. High-optical-performance objective lenses for epi-fluorescence imaging, including the CFI Plan Apochromat Lambda series and the CFI Plan Fluor series, are available.

CI-FL epi-fluorescence attachment and filter cubes
We offer a wide range of objective lenses that are optimal for laboratory and observation work such as the Plan Fluor 10X with its long working distance of 16 mm, and the CFI Plan Apochromat Lambda Series featuring the excellent quality in optical performance.

A 5.9 megapixel CMOS image sensor allows for the capture of images up to 2880 x 2048 pixels with color tones that faithfully represent the specimen.

By connecting the Digital Sight 1000 or DS-Fi3 to a tablet PC with NIS-Elements L installed, images of specimens under observation can be shared with other PCs via a network. The software also contains a variety of measurement and annotation functions.
